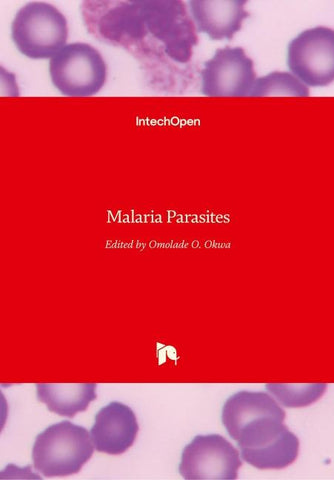
Malaria Parasites

Autorenfreundlich Bücher kaufen?!

Beschreibung
Malaria is a global disease in the world today but most common in the poorest countries of the world, with 90% of deaths occurring in sub-Saharan Africa. This book provides information on global efforts made by scientist which cuts across the continents of the world. Concerted efforts such as symbiont based malaria control; new applications in avian malaria studies; development of humanized mice to study P.falciparium (the most virulent species of malaria parasite); and current issues in laboratory diagnosis will support the prompt treatment of malaria. Research is ultimately gaining more grounds in the quest to provide vaccine for the prevention of malaria. The book features research aimed to bring a lasting solution to the malaria problem and what we should be doing now to face malaria, which is definitely useful for health policies in the twenty first century.
Details
| Verlag | IntechOpen |
| Ersterscheinung | März 2012 |
| Maße | 26.6 cm x 18.5 cm x 3 cm |
| Gewicht | 998 Gramm |
| Format | Hardcover |
| ISBN-13 | 9789535103264 |
| Seiten | 364 |
